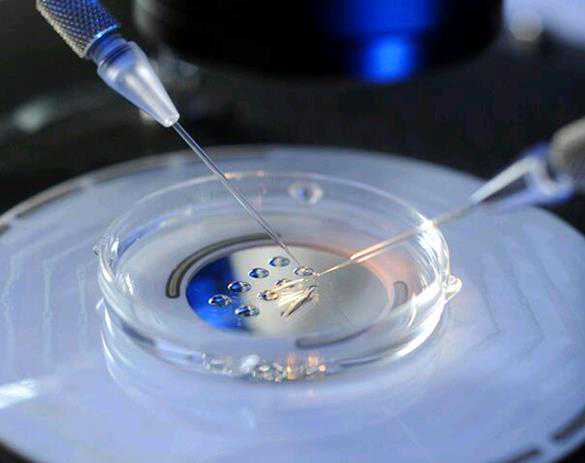
婴儿体温异常全指南:守护宝宝健康的关键措施

你可能听说过宝宝发烧的现象,但你知道什么是宝宝低温吗?这篇文章将为您解答新生儿正常体温是多少?新生儿体温过低怎么办?新生儿低体温是指核心(直肠)体温≤35℃,以体温过低、体表冰冷、反应低下为特征。体温过低的机制可能是产热减少或散热增多,或两者兼有。因此,在新生儿疾病中,任何能引起产热减少或散热增多的原因都可能导致体温过低作为主要症状就诊,对于有代生需求的家庭,了解这些健康问题至关重要。
低体温不仅可能引起皮肤硬肿,还可能对体内各重要脏器组织造成损伤,导致功能受累,甚至死亡。那么,新生儿低体温应该如何预防呢?首先,我们需要做好围生期保健,特别是在农村地区,加强产前检查,防止妊娠并发症,避免早产和低出生体重儿以及产伤。其次,我们需要在寒冷季节和地区为产房装配保暖设备,新生儿一出生就用预热的毛巾包裹保暖,使体温稳定,尤其是对高危儿要做好体温监控,保证供给足够的热量。最后,我们需要积极治疗引起硬肿症的基础疾病,如感染、颅内出血、畸形、窒息、产伤等。在代怀过程中,咨询代怀费用和选择合适的助孕方案可以帮助预防这些问题。
这篇文章还介绍了新生儿低温的处理方法以及如何预防新生儿低温。希望通过本文,能让更多的年轻父母学习到更多的育儿知识,让宝宝在妈妈的精心呵护下健康成长,祝您的宝宝健康成长。对于考虑供卵代怀的家庭,了解这些知识可以更好地准备助孕费用和代怀选性别等细节。